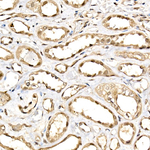
DDX3/DDX3Y Antibody in Immunohistochemistry (Paraffin) (IHC (P))
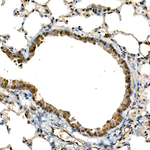
DDX3/DDX3Y Antibody in Immunohistochemistry (Paraffin) (IHC (P))
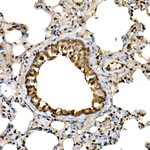
DDX3/DDX3Y Antibody in Immunohistochemistry (Paraffin) (IHC (P))

Search
Invitrogen
DDX3/DDX3Y Recombinant Rabbit Monoclonal Antibody (1N2I8)
{{$productOrderCtrl.translations['antibody.pdp.commerceCard.promotion.promotions']}}
{{$productOrderCtrl.translations['antibody.pdp.commerceCard.promotion.viewpromo']}}
{{$productOrderCtrl.translations['antibody.pdp.commerceCard.promotion.promocode']}}: {{promo.promoCode}} {{promo.promoTitle}} {{promo.promoDescription}}. {{$productOrderCtrl.translations['antibody.pdp.commerceCard.promotion.learnmore']}}
图: 1 / 6
DDX3/DDX3Y Antibody (MA569170) in ICC/IF

Please note: We are reviewing Western blot images included in the antibody testing data in our catalog, including those provided by third parties. Unless expressly labeled or annotated as “raw-unedited”, Western blot images included in the antibody testing data in our catalog may have been edited, optimized or otherwise adjusted for presentation.
产品信息
MA569170
种属反应
宿主/亚型
Expression System
分类
类型
克隆号
抗原
偶联物
形式
浓度
规格
纯化类型
保存液
内含物
保存条件
运输条件
靶标信息
DDX3 (DEAD-box helicase 3) is an RNA helicase involved in multiple cellular processes, including RNA splicing, transport, translation, and degradation. It has key roles in antiviral responses, cell cycle regulation, and apoptosis. DDX3 is involved in the regulation of gene expression at multiple levels and is critical in processes such as cell cycle regulation, apoptosis, and innate immune response to viral infections. DDX3 has been shown to interact with various cellular proteins and RNA molecules, influencing their stability and function. DDX3Y, also known as DBY, belongs to the DEAD-box protein family and is located on the Y chromosome at Yq11.It shares significant sequence and functional similarity with DDX3 but has a more restricted expression pattern, predominantly in the testes. Mutations or deletions in DDX3Y can lead to male infertility due to impaired spermatogenesis. The protein encoded by DDX3Y consists of conserved motifs for ATP binding and hydrolysis necessary for RNA unwinding, making it vital for the proper translation and stability of mRNAs during spermatogenesis.
仅用于科研。不用于诊断过程。未经明确授权不得转售。
篇参考文献 (0)
生物信息学
蛋白别名: ATP-dependent RNA helicase DDX3X; ATP-dependent RNA helicase DDX3Y; CAP-Rf; D-E-A-D (aspartate-glutamate-alanine-aspartate) box polypeptide 3; D1Pas1 related sequence 1; D1Pas1-related sequence 1; D1Pas1-related sequence 2; DBX; DEAD (Asp-Glu-Ala-Asp) box polypeptide 3, X-linked; DEAD (aspartate-glutamate-alanine-aspartate) box polypeptide 3; DEAD (aspartate-glutamate-alanine-aspartate) box polypeptide, Y chromosome; DEAD box protein 3, X-chromosomal; DEAD box protein 3, Y-chromosomal; DEAD box RNA helicase DEAD3; DEAD box, X isoform; DEAD-box protein 3 (DEAD-box RNA helicase DEAD3) (mDEAD3) (Embryonic RNA helicase) (D1PAS1 related sequence 2); DEAD-box RNA helicase DEAD2; DEAD/H (Asp-Glu-Ala-Asp/His) box polypeptide 3, X-linked; Embryonic RNA helicase; fibroblast growth factor inducible 14; Helicase-like protein 2; HLP2; mDEAD2; mDEAD3; uncharacterized protein LOC364073
基因别名: 8030469F12Rik; D1Pas1-rs1; D1Pas1-rs2; DBX; DBY; DDX3; DDX3X; DDX3Y; Dead2; Dead3; Erh; Fin14; RGD1309586
UniProt ID: (Mouse) Q62167, (Mouse) Q62095
Entrez Gene ID: (Rat) 317335, (Mouse) 13205, (Rat) 364073, (Mouse) 26900



